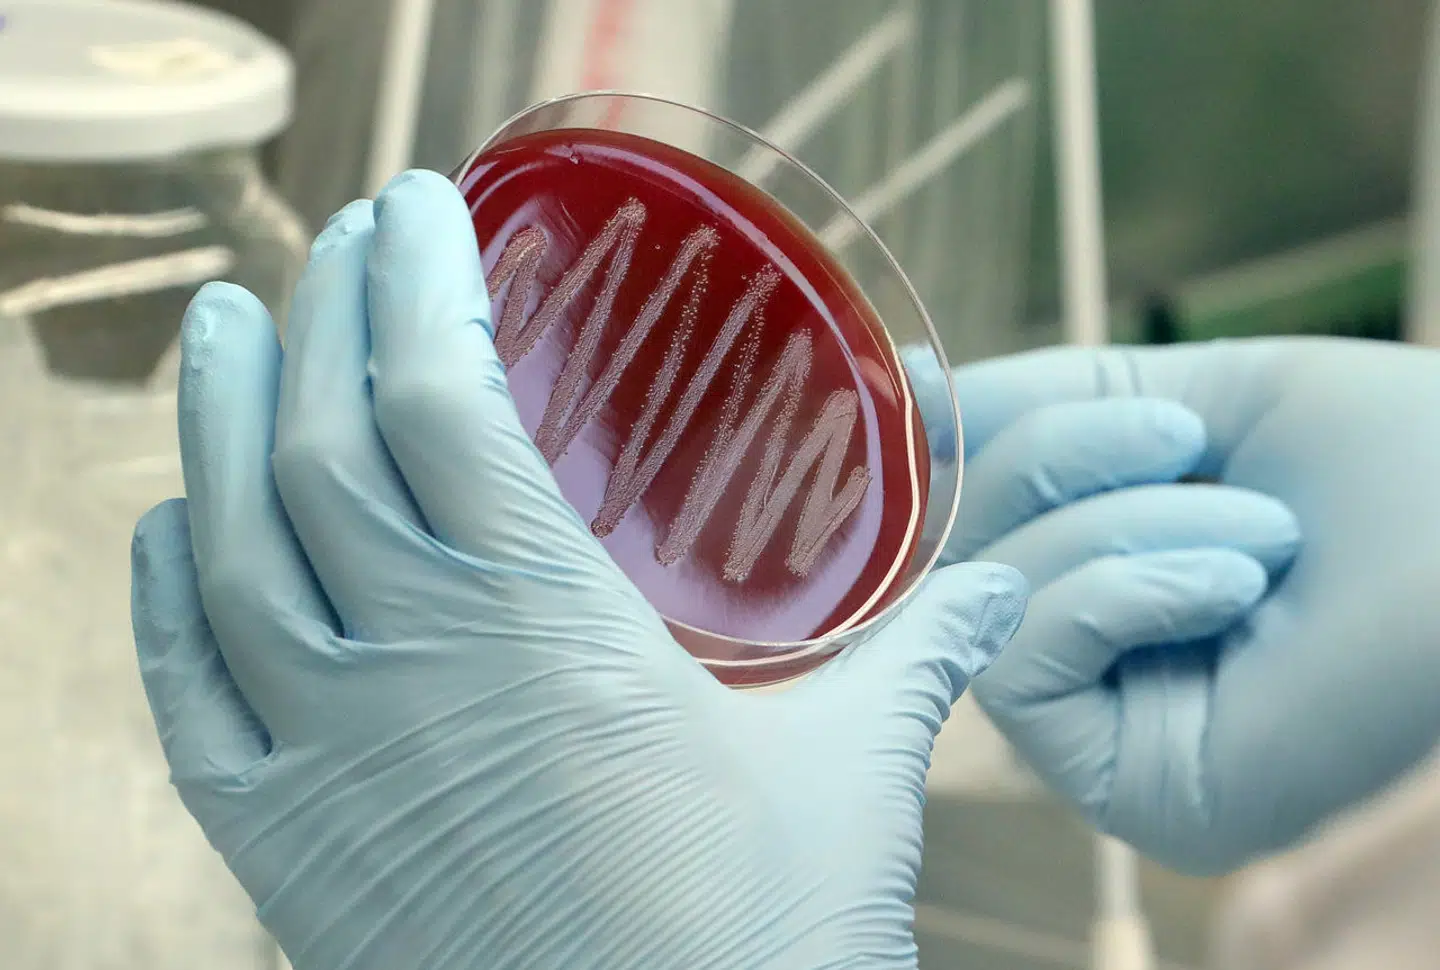

Efter talrige prøvelser med hænderne fast plantet på rattet er overstået, lander afgørelsen:
Har man gjort sig fortjent til et kørekort, eller skal man give det endnu et forsøg?
I København skal en stor del aflægge endnu et besøg hos den sagkyndige, efter at de har foretaget den endelige parkering til køreprøven.
En kortlægning fra Taxa 4x35 med tal fra Færdselsstyrelsen viser nemlig, at København ligger i bunden, når det gælder køre- og teoriprøver. Det er ikke første gang, at det er sket.
I sommer skrev TV 2 Kosmopol om samme problematik, og i den forbindelse talte de med formanden for Dansk Kørelærer-Union, Bent Grue
»Trafiktætheden er en stor årsag til det. Når man kommer ind til København, må man sige, at der er flere cyklister og fodgængere at holde øje med, end der er i Tønder. Det gør det sværere at tage kørekort i hovedstaden,« sagde han.
Bent Grue mente ikke udelukkende, at de mange dumpede køreprøver skyldtes trafiktætheden. Robotter var ifølge kørelæreren også en del af årsagen til de mange dumpede køreprøver i hovedstaden.
Flere kørelærere i hovedstadsområdet bruger nemlig robotter til at booke køreprøver, da de kan booke hurtigere, end hvis kørelæreren skulle gøre det selv. Og det betyder, at køreprøven sommetider bliver booket, før eleven er helt klar til prøven.
Her er et overblik over, hvordan de forskellige kredse i Danmark klarer køre- og teoriprøven.